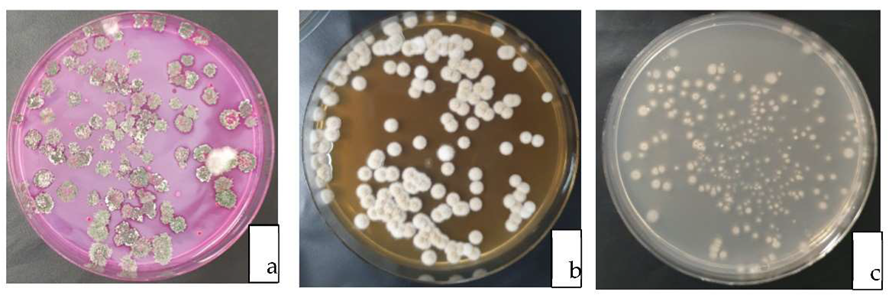
Jof 09 00067 g003

Testing the Biocontrol Ability of a Trichoderma-Streptomycetes Consortium against Pyrrhoderma noxium (Corner) L.W. Zhou and Y.C. Dai in Soil
Abstract
1. Introduction
2. Materials and Methods
2.1. Details of the Biological Control Agents and Pathogen Used
2.2. In Vitro Evaluation of the Antagonistic Potential of Trichoderma Strains and Streptomycetes on P. noxium Using Wood Block Test
2.2.1. Effect of BCAs in Protecting the Weight Loss in P. noxium Treated Wood Blocks
2.2.2. Effect of BCAs on Protecting the Strength of P. noxium Treated Wood Blocks
2.2.3. Inhibitory Effect of Biological Control Agents on the Establishment of P. noxium on Wood Blocks
2.3. Pot Experiment
2.3.1. Treatment Selection and Container Media Inoculations
2.3.2. Effect of Pathogen and Biological Control Agents on the Growth Parameters of Fig Plants
2.3.3. Inhibitory Effect of Biological Control Agents on the Establishment of P. noxium in Plant Roots
2.4. Statistical Analysis
3. Results
3.1. In Vitro Evaluation of the Antagonistic Potential of Trichoderma Strains and Streptomycetes on P. noxium Using a Wood Block Test
3.1.1. Effect of BCAs in Preventing the Weight Loss and Strength of P. noxium Treated Wood Blocks
3.1.2. Inhibitory Effect of Biological Control Agents on the Establishment of P. noxium on Wood Blocks
3.2. Pot Experiment
3.2.1. Re-Isolation of the Pathogen and BCA from Container Media
3.2.2. Effect of Pathogen and Biological Control Agents on the Growth Parameters of Fig Plants
3.2.3. Inhibitory Effect of Biological Control Agents on the Establishment of P. noxium in Plant Roots
4. Discussion
5. Conclusions
Author Contributions
Funding
Institutional Review Board Statement
Informed Consent Statement
Data Availability Statement
Acknowledgments
Conflicts of Interest
References
- Ann, P.J.; Chang, T.T.; Ko, W.H. Phellinus noxius brown root rot of fruit and ornamental trees in Taiwan. Plant Dis. 2002, 86, 820–826. [Google Scholar] [CrossRef] [PubMed]
- Schwarze, F.W.M.R.; Jauss, F.; Spencer, C.; Hallam, C.; Schubert, M. Evaluation of an antagonistic Trichoderma strain for reducing the rate of wood decomposition by the white rot fungus Phellinus noxius. J. Biocontrol. 2012, 61, 160–168. [Google Scholar] [CrossRef]
- Ribera, J.; Tang, A.M.C.; Schubert, M.; Lam, R.Y.C.; Chu, L.M.; Leung, M.W.K.; Schwarze, F.W.M.R. In vitro evaluation of antagonistic Trichoderma strains for eradicating Phellinus noxius in colonised wood. J. Trop. For. Sci. 2016, 28, 457–468. [Google Scholar]
- Chou, H.; Xiao, Y.T.; Tsai, J.N.; Li, T.T.; Wu, H.Y.; Liu, L.D.; Chung, C.L. In Vitro and in planta evaluation of Trichoderma asperellum TA as a biocontrol agent against Phellinus noxius, the cause of brown root rot disease of trees. Plant Dis. 2019, 103, 2733–2741. [Google Scholar] [CrossRef] [PubMed]
- Chang, T.T. Survival of Phellinus noxius in soil and in the roots of dead host plants. Phytopathology 1996, 86, 272–276. [Google Scholar] [CrossRef]
- Tsai, J.N.; Ann, P.J.; Hsieh, W.H. Evaluation of fungicides for suppression of three major wood-decay fungi Phellinus noxius, Rosellinia necatrix and Ganoderma australe in Taiwan. Plant Pathol. Bull. 2005, 14, 115–124. [Google Scholar]
- Vinale, F.; Sivasithamparam, K.; Ghisalberti, E.L.; Marra, R.; Woo, S.L.; Lorito, M. Trichoderma–plant–pathogen interactions. Soil Biol. Biochem. 2008, 40, 1–10. [Google Scholar] [CrossRef]
- Surekha, C.; Neelapu, N.R.R.; Prasad, B.; Ganesh, P. Induction of defence enzymes and phenolic content by Trichoderma viride in Vigna mungo infested with Fusarium oxysporum and Alternaria alternata. Int. J. Pharm. Biol. Arch. 2014, 4, 31–40. [Google Scholar]
- Ulloa-Ogaz, A.; Muñoz-Castellanos, L.; Nevarez-Moorillon, G. Biocontrol of phytopathogens: Antibiotic production as mechanism of control, the battle against microbial pathogens. In Basic Science, Technological Advance and Educational Programs; Mendez Vilas, A., Ed.; Formatex Research Center: Badajoz, Spain, 2015; Volume 1, pp. 305–309. [Google Scholar]
- Barratt, B.; Moran, V.; Bigler, F.; Van Lenteren, J.C. The status of biological control and recommendations for improving uptake for the future. BioControl 2018, 63, 155–167. [Google Scholar] [CrossRef]
- Liu, K.; McInroy, J.A.; Hu, C.H.; Kloepper, J.W. Mixtures of plant-growth-promoting rhizobacteria enhance biological control of multiple plant diseases and plant-growth promotion in the presence of pathogens. Plant Dis. 2018, 102, 67–72. [Google Scholar] [CrossRef]
- Köhl, J.; Kolnaar, R.; Ravensberg, W.J. Mode of action of microbial biological control agents against plant diseases: Relevance beyond efficacy. Plant Sci. 2019, 10, 845. [Google Scholar] [CrossRef]
- El-Tarabily, K.A.; Sykes, M.L.; Kurtböke, I.D.; Hardy, G.E.S.J.; Barbosa, A.M.; Dekker, R.F. Synergistic effects of a cellulase-producing Micromonospora carbonacea and an antibiotic-producing Streptomyces violascens on the suppression of Phytophthora cinnamomi root rot of Banksia grandis. Can. J. Bot. 1996, 74, 618–624. [Google Scholar] [CrossRef]
- Valois, D.; Fayad, K.; Barasubiye, T.; Garon, M.; Dery, C.; Brzezinski, R.; Beaulieu, C. Glucanolytic Actinomycetes Antagonistic to Phytophthora fragariae var. rubi, the Causal Agent of Raspberry Root Rot. Appl. Environ. Microbiol. 1996, 62, 1630–1635. [Google Scholar] [CrossRef]
- Mathivanan, N.; Srinivasan, K.; Chelliah, S. Biological control of soil-borne diseases of cotton, eggplant, okra and sunflower by Trichoderma viride. J. Plant Dis. Prot. 2000, 107, 235–244. [Google Scholar]
- Sabaratnam, S.; Traquair, J.A. Formulation of a Streptomyces Biocontrol Agent for the Suppression of Rhizoctonia Damping-off in Tomato Transplants. Biol. Control 2002, 23, 245–253. [Google Scholar] [CrossRef]
- Ezziyyani, M.; Requena, M.E.; Egea-Gilabert, C.; Candela, M.E. Biological Control of Phytophthora Root Rot of Pepper Using Trichoderma harzianum and Streptomyces rochei in Combination. Int. J. Environ. Sci. 2007, 155, 342–349. [Google Scholar] [CrossRef]
- Ommati, F.; Zaker, M. In vitro and greenhouse evaluations of Trichoderma isolates for biological control of potato wilt disease (Fusarium solani). Arch. Phytopathol. Plant Prot. 2012, 45, 1715–1723. [Google Scholar] [CrossRef]
- El-Sharkawy, H.; Tohamey, S.; Khalil, A. Combined effects of Streptomyces viridosporus and Trichoderma harzianum on controlling wheat leaf rust caused by Puccinia triticina. Plant Pathol. J. 2015, 14, 182–188. [Google Scholar] [CrossRef]
- Faheem, M.; Raza, W.; Zhong, W.; Nan, Z.; Shen, Q.; Xu, Y. Evaluation of the biocontrol potential of Streptomyces goshikiensis YCXU against Fusarium oxysporum f. sp. Niveum. Biol. Control 2015, 81, 101–110. [Google Scholar] [CrossRef]
- Sharma, V.; Salwan, R. Biocontrol potential and applications of actinobacteria in agriculture, in new and future developments in microbial biotechnology and bioengineering. In New and Future Developments in Microbial Biotechnology and Bioengineering, 1st ed.; Singh, B.P., Gupta, V.K., Passari, A.K., Eds.; Elsevier: Amsterdam, The Netherlands, 2018; pp. 93–108. [Google Scholar] [CrossRef]
- Uddin, M.N.; ur Rahman, U.; Khan, W.; Uddin, N.; Muhammad, M. Effect of Trichoderma harzianum on tomato plant growth and its antagonistic activity against Phythium ultimum and Phytopthora capsici. Egypt. J. Biol. Pest Control 2018, 28, 32. [Google Scholar] [CrossRef]
- Wu, Q.; Ni, M.; Dou, K.; Tang, J.; Ren, J.; Yu, C.; Chen, J. Co-culture of Bacillus amyloliquefaciens ACCC11060 and Trichoderma asperellum GDFS1009 enhanced pathogen-inhibition and amino acid yield. Microb. Cell Fact. 2018, 17, 155. [Google Scholar] [CrossRef]
- Kaur, T.; Rani, R.; Manhas, R.K. Biocontrol and plant growth promoting potential of phylogenetically new Streptomyces sp. MR14 of rhizospheric origin. AMB Express 2019, 9, 125. [Google Scholar] [CrossRef]
- Ketta, H.A.; Elkhateeb, N.M.; Saleh, M.M.; Kamel, S.M. Efficiency Assessment of Combinations Between Rhizobium leguminosarum and Trichoderma spp. for Controlling of Pea (Pisum sativum L.) Damping-off Disease. Egypt. J. Phytopathol. 2021, 49, 1–14. [Google Scholar] [CrossRef]
- Solanki, M.K.; Yandigeri, M.S.; Kumar, S.; Singh, R.K.; Srivastava, A.K. Co-inoculation of different antagonists can enhance the biocontrol activity against Rhizoctonia solani in tomato. Antonie Van Leeuwenhoek 2019, 112, 1633–1644. [Google Scholar] [CrossRef]
- Izquierdo-García, L.F.; González-Almario, A.; Cotes, A.M.; Moreno-Velandia, C.A. Trichoderma virens Gl006 and Bacillus velezensis Bs006: A compatible interaction controlling Fusarium wilt of cape gooseberry. Sci. Rep. 2020, 10, 6857. [Google Scholar] [CrossRef]
- Yanti, Y.; Zainon, M.N.; Marshida, A.H.U. Antagonistic activity of three Actinomycetes, MG01, MG02 And KT2F towards Phellinus noxius. In Proceedings of the IEEE Symposium on Business, Engineering and Industrial Applications, Bandung, Indonesia, 23–26 September 2012; Volume 1, pp. 729–732. [Google Scholar]
- Yaacob, Y. Biocontrol of Plant Pathogen Phellinus noxius by Selected Actinomycetes, Bacteria and Fungi. Ph.D. Thesis, Universiti Teknologi MARA, Shah Alam, Malaysia, 2014. [Google Scholar]
- Broadbent, P.; Baker, K.F.; Waterworth, Y. Bacteria and actinomycetes antagonistic to fungal root pathogens in Australian soils. Aust. J. Biol. Sci. 1971, 24, 925–944. [Google Scholar] [CrossRef]
- Kurtböke, D.; French, J.R.J. Actinobacterial resources from termite guts for regional bioindustries. Microbiol. Aust. 2008, 29, 42. [Google Scholar] [CrossRef][Green Version]
- Panchalingam, H.; Powell, D.; Adra, C.; Foster, K.; Tomlin, R.; Quigley, B.L.; Nyari, S.; Hayes, R.A.; Shapcott, A.; Kurtböke, D.K. Assessing the various antagonistic mechanisms of Trichoderma strains against the brown root rot pathogen Pyrrhoderma noxium infecting heritage fig trees. J. Fungi 2022, 8, 1105. [Google Scholar] [CrossRef] [PubMed]
- Schwarze, F.W.M.R.; Fink, S. Host and cell type affect the mode of degradation by Meripilus giganteus. New Phytol. 1998, 139, 721–731. [Google Scholar] [CrossRef]
- Kangas, M.; Filip, G.M.; Morrell, J.J. Effect of fire charring on condition of Ponderosa pine trees in Oregon as measured by longitudinal compression strength. West. J. Appl. For. 2009, 24, 33–35. [Google Scholar] [CrossRef][Green Version]
- Chang, T.T. A selective medium for Phellinus noxins. Eur. J. For. Pathol. 1995, 25, 185–190. [Google Scholar] [CrossRef]
- Maxwell, S.E. Completely randomized design. In Encyclopedia of Statistics in Behavioral Science; John Wiley & Sons, Ltd.: Hoboken, NJ, USA, 2005. [Google Scholar] [CrossRef]
- Küster, E.; Williams, S.T. Selection of Media for Isolation of Streptomycetes. Nature 1964, 202, 928–929. [Google Scholar] [CrossRef]
- Askew, D.J.; Laing, M.D. An adapted selective medium for the quantitative isolation of Trichoderma species. Plant Pathol. 1993, 42, 686–690. [Google Scholar] [CrossRef]
- Williams, J.; Clarkson, J.M.; Mills, P.R.; Cooper, R.M. A selective medium for quantitative reisolation of Trichoderma harzianum from Agaricus bisporus Compost. Appl. Environ. Microb. 2003, 69, 4190–4191. [Google Scholar] [CrossRef][Green Version]
- IBM Corporation. IBM SPSS Statistics for Windows; Version 26.0; IBM Corporation: Armonk, NY, USA, 2019. [Google Scholar]
- Nicole, M.; Chamberland, H.; Rioux, D.; Xixuan, X.; Blanchette, R.A.; Geiger, J.P.; Ouellete, G.B. Wood degradation by Phellinus noxius: Ultrastructure and cytochemistry. Can. J. Microbiol. 1995, 41, 253–265. [Google Scholar] [CrossRef]
- Burcham, D.C.; Wong, J.Y.; Abarrientos, N.V.; Mohamed Ali, M.I.; Fong, Y.K.; Schwarze, F.W.M.R. In vitro evaluation of antagonism by Trichoderma spp. towards Phellinus noxius associated with rain tree (Samanea saman) and Senegal mahogany (Khaya senegalensis) in Singapore. bioRxiv 2017, 151753. [Google Scholar] [CrossRef]
- Jung, S.J.; Kim, N.K.; Lee, D.H.; Hong, S.I.; Lee, J.K. Screening and evaluation of Streptomyces species as a potential biocontrol agent against a wood decay fungus, Gloeophyllum trabeum. Mycobiology 2018, 46, 138–146. [Google Scholar] [CrossRef]
- Goodell, B.; Winandy, J.E.; Morrell, J.J. Fungal degradation of wood: Emerging data, new insights and changing perceptions. Coatings 2020, 10, 1210. [Google Scholar] [CrossRef]
- Lee, S.Y.; Tindwa, H.; Lee, Y.S.; Naing, K.W.; Hong, S.H.; Nam, Y.; Kim, K.Y. Biocontrol of anthracnose in pepper using chitinase, beta-1,3 glucanase, and 2-furancarboxaldehyde produced by Streptomyces cavourensis SY224. J. Microbiol. Biotechnol. 2012, 22, 1359–1366. [Google Scholar] [CrossRef]
- Adnan, M.; Islam, W.; Shabbir, A.; Khan, K.A.; Ghramh, H.A.; Huang, Z.; Lu, G.D. Plant defense against fungal pathogens by antagonistic fungi with Trichoderma in focus. Microb. Pathog. 2019, 129, 7–18. [Google Scholar] [CrossRef]
- Ghasemi, S.; Safaie, N.; Shahbazi, S.; Shams-Bakhsh, M.; Askari, H. The role of cell wall degrading enzymes in antagonistic traits of Trichoderma virens against Rhizoctonia solani. Iran. J. Biotechnol. 2020, 18, e2333. [Google Scholar] [CrossRef] [PubMed]
- Boukaew, S.; Cheirsilp, B.; Prasertsan, P.; Yossan, S.S. Antifungal effect of volatile organic compounds produced by Streptomyces salmonis PSRDC-09 against anthracnose pathogen Colletotrichum gloeosporioides PSU-03 in postharvest chili fruit. J. Appl. Microbiol. 2021, 131, 1452–1463. [Google Scholar] [CrossRef] [PubMed]
- Li, S.; Yang, B.; Tan, G.Y.; Ouyang, L.M.; Qiu, S.; Wang, W.; Zhang, L. Polyketide pesticides from actinomycetes. Curr. Opin. Biotechnol. 2021, 69, 299–307. [Google Scholar] [CrossRef] [PubMed]
- Sarria, G.; Garcia, A.; Mestizo, Y.; Medina, C.; VarÓN, F.; Mesa, E.; Hernandez, S. Antagonistic interactions between Trichoderma spp. and Phytophthora palmivora (Butler) from oil palm in Colombia. Eur. J. Plant Pathol. 2021, 161, 751–768. [Google Scholar] [CrossRef]
- Sari, M.; Nawangsih, A.A.; Wahyudi, A.T. Rhizosphere Streptomyces formulas as the biological control agent of phytopathogenic fungi Fusarium oxysporum and plant growth promoter of soybean. Biodiversitas J. Biol. Divers. 2021, 22. [Google Scholar] [CrossRef]
- Yu, Z.; Liu, Z.; Zhang, Y.; Wang, Z. The disease resistance potential of Trichoderma asperellum T-Pa2 isolated from Phellodendron amurense rhizosphere soil. J. For. Res. 2022, 33, 321–331. [Google Scholar] [CrossRef]
- Idowu, O.; Christopher, O.; Salami, A.O. The interactive effects of three Trichoderma species and dampingoff causative pathogen Pythium aphanidermatum on emergence indices, infection incidence and growth performance of sweet pepper. Int. J. Recent Sci. Res. 2016, 7, 10339–10347. [Google Scholar]
- Gopalakrishnan, S.; Pande, S.; Sharma, M.; Humayun, P.; Kiran, B.K.; Sandeep, D.; Rupela, O. Evaluation of actinomycete isolates obtained from herbal vermicompost for the biological control of Fusarium wilt of chickpea. Crop Prot. 2011, 30, 1070–1078. [Google Scholar] [CrossRef]
- Law, J.W.F.; Ser, H.L.; Khan, T.M.; Chuah, L.H.; Pusparajah, P.; Chan, K.G.; Lee, L.H. The potential of Streptomyces as biocontrol agents against the rice blast fungus, Magnaporthe oryzae (Pyricularia oryzae). Front. Microbiol. 2017, 8, 3. [Google Scholar] [CrossRef]
- Gangwar, M.; Kaur, N.; Saini, P.; Kalia, A. The diversity, plant growth promoting and anti-microbial activities of endophytic actinomycetes isolated from Emblica officinalis Gaertn. Int. J. Adv. Res. 2015, 3, 1062–1071. [Google Scholar]
- Marmann, A.; Aly, A.H.; Lin, W.; Wang, B.; Proksch, P. Co-Cultivation—A Powerful Emerging Tool for Enhancing the Chemical Diversity of Microorganisms. Mar. Drugs 2014, 12, 1043–1065. [Google Scholar] [CrossRef]
- Netzker, T.; Fischer, J.; Weber, J.; Mattern, D.J.; König, C.C.; Valiante, V.; Brakhage, A.A. Microbial communication leading to the activation of silent fungal secondary metabolite gene clusters. Front. Microbiol. 2015, 6, 299. [Google Scholar] [CrossRef]
- Altomare, C.; Norvell, W.A.; Björkman, T.; Harman, G.E. Solubilization of phosphates and micronutrients by the plant-growth-promoting and biocontrol fungus Trichoderma harzianum Rifai 1295-22. Appl. Environ. Microbiol. 1999, 65, 2926–2933. [Google Scholar] [CrossRef]
- Jaroszuk-Ściseł, J.; Tyśkiewicz, R.; Nowak, A.; Ozimek, E.; Majewska, M.; Hanaka, A.; Janusz, G. Phytohormones (Auxin, Gibberellin) and ACC Deaminase In Vitro synthesized by the mycoparasitic Trichoderma DEMTkZ3A0 strain and changes in the level of auxin and plant resistance markers in wheat seedlings inoculated with this strain conidia. Int. J. Mol. Sci. 2019, 20, 4923. [Google Scholar] [CrossRef]
- Contreras-Cornejo, H.A.; Macías-Rodríguez, L.; del-Val, E.; Larsen, J. Interactions of Trichoderma with plants, insects, and plant pathogen microorganisms: Chemical and molecular bases. In Co-Evolution of Secondary Metabolites; Springer: Cham, Switzerland, 2018; pp. 263–290. [Google Scholar]
- Chen, D.; Hou, Q.; Jia, L.; Sun, K. Combined use of two Trichoderma strains to promote growth of pakchoi (Brassica chinensis L.). Agronomy 2021, 11, 726. [Google Scholar] [CrossRef]
- Illescas, M.; Pedrero-Méndez, A.; Pitorini-Bovolini, M.; Hermosa, R.; Monte, E. Phytohormone production profiles in Trichoderma species and their relationship to wheat plant responses to water stress. Pathogens 2021, 10, 991. [Google Scholar] [CrossRef]

| Treatment | Inocula |
|---|---|
| Trichoderma consortium (T) | Trichoderma strains (#5001 and #5029) |
| Streptomycetes consortium (S) | Streptomycetes (#USC−6914 and #USC−595−B) |
| P. noxium (P) | P. noxium strains (A, B, D, E and F) |
| Trichoderma consortium and streptomycetes consortium together (TS) | Trichoderma strains (#5001 and #5029) with streptomycetes (#USC−6914 and #USC−595−B) |
| Streptomycetes consortium with P. noxium (SP) | P. noxium strains (A, B, D, E and F) with streptomycetes (#USC-6914 and #USC−595−B) |
| Trichoderma consortium with P. noxium (TP) | P. noxium strains (A, B, D, E and F) with Trichoderma strains (#5001 and #5029) |
| Trichoderma consortium, streptomycetes consortium and P. noxium (TSP) | P. noxium strains (A, B, D, E and F) with Trichoderma strains (#5001 and #5029) and streptomycetes (#USC−6914 and #USC−595−B) |
| Control | Without any inoculation of the above listed BCAs or the pathogen |
| Treatments | Ratio of Outer Wood Segments * | Isolation Frequency (Outer Surface) % | Ratio of Inner Wood Segments * | Isolation Frequency (Inner Surface) % |
|---|---|---|---|---|
| P. noxium (P) | 23/25 | 92 | 25/25 | 100 |
| Trichoderma consortium with P. noxium (TP) | 2/25 | 8 | 0/25 | 0 |
| Streptomycetes consortium with P. noxium (SP) | 3/25 | 12 | 0/25 | 0 |
| All the BCAs with P. noxium (TSP) | 0/25 | 0 | 0/25 | 0 |
| Treatments | Ratio of Root Fragments * | P. noxium Isolation Frequency (%) |
|---|---|---|
| P. noxium (P) | 52/60 | 86.67 |
| Trichoderma consortium + P. noxium (TP) | 5/60 | 8.33 |
| Streptomycetes consortium + P. noxium (SP) | 7/60 | 11.67 |
| P. noxium with all the BCAs (TSP) | 0/60 | 0 |
Disclaimer/Publisher’s Note: The statements, opinions and data contained in all publications are solely those of the individual author(s) and contributor(s) and not of MDPI and/or the editor(s). MDPI and/or the editor(s) disclaim responsibility for any injury to people or property resulting from any ideas, methods, instructions or products referred to in the content. |
© 2022 by the authors. Licensee MDPI, Basel, Switzerland. This article is an open access article distributed under the terms and conditions of the Creative Commons Attribution (CC BY) license (https://creativecommons.org/licenses/by/4.0/).
Share and Cite
Panchalingam, H.; Ashfield-Crook, N.; Naik, V.; Frenken, R.; Foster, K.; Tomlin, R.; Shapcott, A.; Kurtböke, D.İ. Testing the Biocontrol Ability of a Trichoderma-Streptomycetes Consortium against Pyrrhoderma noxium (Corner) L.W. Zhou and Y.C. Dai in Soil. J. Fungi 2023, 9, 67. https://doi.org/10.3390/jof9010067
Panchalingam H, Ashfield-Crook N, Naik V, Frenken R, Foster K, Tomlin R, Shapcott A, Kurtböke Dİ. Testing the Biocontrol Ability of a Trichoderma-Streptomycetes Consortium against Pyrrhoderma noxium (Corner) L.W. Zhou and Y.C. Dai in Soil. Journal of Fungi. 2023; 9(1):67. https://doi.org/10.3390/jof9010067
Chicago/Turabian StylePanchalingam, Harrchun, Nina Ashfield-Crook, Vatsal Naik, Richard Frenken, Keith Foster, Russell Tomlin, Alison Shapcott, and D. İpek Kurtböke. 2023. "Testing the Biocontrol Ability of a Trichoderma-Streptomycetes Consortium against Pyrrhoderma noxium (Corner) L.W. Zhou and Y.C. Dai in Soil" Journal of Fungi 9, no. 1: 67. https://doi.org/10.3390/jof9010067
APA StylePanchalingam, H., Ashfield-Crook, N., Naik, V., Frenken, R., Foster, K., Tomlin, R., Shapcott, A., & Kurtböke, D. İ. (2023). Testing the Biocontrol Ability of a Trichoderma-Streptomycetes Consortium against Pyrrhoderma noxium (Corner) L.W. Zhou and Y.C. Dai in Soil. Journal of Fungi, 9(1), 67. https://doi.org/10.3390/jof9010067








